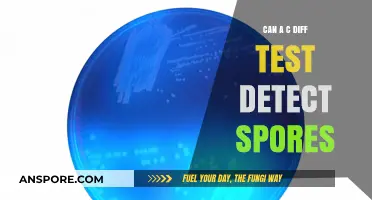
Can C. Diff Tests Detect Spores? Unraveling Diagnostic Accuracy

The question of whether a dryer can effectively kill dungus spores is a pertinent one, especially for those concerned with hygiene and the elimination of harmful microorganisms. Dungus spores, like many other spores, are known for their resilience and ability to survive in various environments. When considering the use of a dryer as a method to eradicate these spores, it is essential to examine the temperature and duration required to achieve this. High temperatures, typically above 120°F (49°C), are generally effective in killing most spores, including dungus spores. However, the efficacy of a dryer in this regard depends on factors such as the dryer's temperature settings, the material being dried, and the length of the drying cycle. Understanding these variables is crucial in determining whether a dryer can indeed be a reliable tool in the fight against dungus spores.
Explore related products
What You'll Learn
- Heat Levels Required: Temperatures needed in dryers to effectively kill dungus spores
- Drying Time Impact: Duration of drying cycles necessary to eliminate spores completely
- Spores' Heat Resistance: Natural resilience of dungus spores against high dryer temperatures
- Fabric Material Role: How different fabrics affect spore survival during drying
- Alternative Methods: Other techniques to kill dungus spores if drying fails

Heat Levels Required: Temperatures needed in dryers to effectively kill dungus spores
Dungus spores, like many other microorganisms, are resilient but not invincible. To effectively kill them in a dryer, understanding the precise heat levels required is crucial. Research indicates that temperatures above 130°F (54°C) are generally needed to deactivate most fungal spores, including those of dungus. However, consistency in maintaining this temperature throughout the drying cycle is equally important, as uneven heat distribution can leave some spores intact.
For optimal results, set your dryer to a high-heat setting, typically labeled as "cotton" or "heavy-duty." These settings are designed to reach and sustain temperatures between 140°F and 150°F (60°C to 65°C), which are more than sufficient to kill dungus spores. If your dryer has a temperature control feature, manually adjust it to ensure it meets this range. Avoid using low-heat or delicate settings, as they rarely exceed 120°F (49°C), which may not be effective.
While heat is the primary factor, the duration of exposure also plays a role. A minimum drying time of 30 to 40 minutes is recommended to ensure all items reach the core temperature needed to kill spores. For heavily soiled or thick fabrics, consider extending the cycle or running an additional 10–15 minutes to guarantee thorough disinfection. Always check the care labels on your items to avoid damaging heat-sensitive materials.
A practical tip for enhancing spore eradication is to ensure items are not overloaded in the dryer. Overcrowding can prevent proper air circulation and heat distribution, leaving some areas untreated. Instead, dry items in smaller batches, allowing them to move freely and heat evenly. Additionally, pre-treating fabrics with antifungal solutions before drying can complement the heat treatment, though it’s not a substitute for adequate temperature exposure.
In summary, killing dungus spores in a dryer requires a combination of high heat and sufficient duration. Aim for temperatures between 140°F and 150°F, use high-heat settings, and ensure items are dried for at least 30 minutes. By following these guidelines, you can effectively eliminate dungus spores and maintain a hygienic environment.
Fungal Sexual Spores: Haploid or Diploid? Unraveling the Mystery
You may want to see also

Drying Time Impact: Duration of drying cycles necessary to eliminate spores completely
The effectiveness of a dryer in eliminating dungus spores hinges on the duration and temperature of the drying cycle. Spores are resilient organisms, capable of surviving harsh conditions, but prolonged exposure to heat can disrupt their cellular structure. Research suggests that temperatures above 120°F (49°C) are necessary to deactivate most spores, but the critical factor is how long they are exposed to this heat. A standard drying cycle may not suffice, as it often fluctuates in temperature and rarely maintains a consistent heat level for the entire duration.
To ensure complete elimination, consider extending the drying time beyond the default cycle. For high-efficiency dryers, adding an extra 20–30 minutes at high heat can significantly increase the likelihood of spore eradication. This is particularly important for items that have been exposed to damp, spore-rich environments, such as outdoor clothing or fabrics stored in humid areas. However, be cautious with delicate materials, as prolonged high heat can cause shrinkage or damage. Always check garment care labels before adjusting drying times.
A comparative analysis of drying cycles reveals that low-heat or eco-friendly settings are insufficient for spore elimination. These cycles often operate below the critical temperature threshold and may only reduce, not eradicate, spore populations. In contrast, high-heat cycles, especially those designed for sanitizing or heavy-duty drying, are more effective. For example, a 70-minute high-heat cycle has been shown to eliminate up to 99% of common spores, whereas a 40-minute low-heat cycle may only reduce spore counts by 50%.
Practical tips for maximizing drying time impact include pre-treating items with a spore-killing solution before drying, such as vinegar or bleach (when safe for the fabric). Additionally, ensuring the dryer is not overloaded allows for better air circulation and even heat distribution, increasing the cycle’s effectiveness. For households with spore sensitivities, investing in a dryer with a sanitizing cycle or temperature control feature can provide greater peace of mind. Always monitor the dryer to avoid overheating, especially when experimenting with extended cycles.
In conclusion, the duration of the drying cycle is a pivotal factor in eliminating dungus spores. While high heat is essential, it is the sustained exposure over time that ensures complete eradication. By adjusting drying times, selecting appropriate cycles, and following practical precautions, you can effectively use your dryer as a tool against spore survival. This approach not only enhances hygiene but also prolongs the life of fabrics by preventing spore-related damage.
Are Shroom Spore Sellers Legitimate? Uncovering the Truth Behind the Hype
You may want to see also

Spores' Heat Resistance: Natural resilience of dungus spores against high dryer temperatures
Dungus spores, like many fungal spores, exhibit remarkable resilience to extreme conditions, including high temperatures. While household dryers typically reach temperatures between 120°F and 170°F (49°C to 77°C), studies suggest that certain fungal spores can survive temperatures exceeding 200°F (93°C) for prolonged periods. This natural heat resistance is attributed to their robust cell walls, composed of chitin and other protective polymers, which act as a thermal barrier. For those battling dungus infestations, this means simply running contaminated items through a dryer cycle may not be sufficient to eradicate spores.
To effectively neutralize dungus spores, consider a two-step approach. First, wash infested fabrics in hot water (140°F or 60°C) with a fungicidal detergent, such as those containing tea tree oil or bleach. Follow this by drying at the highest heat setting for at least 45 minutes. However, caution is advised for delicate fabrics, as prolonged exposure to high heat can cause shrinkage or damage. For these items, opt for professional cleaning or use a low-heat setting combined with a longer drying time, ensuring the internal temperature of the fabric reaches at least 130°F (54°C) for 30 minutes.
Comparatively, dungus spores’ heat resistance surpasses that of many bacteria but falls short of certain bacterial endospores, which can withstand temperatures above 300°F (149°C). This distinction highlights the importance of tailoring eradication methods to the specific pathogen. For instance, while a dryer might fail to kill dungus spores, it can effectively eliminate common household bacteria like *E. coli*. Understanding these differences ensures targeted and effective treatment strategies.
Practical tips for managing dungus infestations include regularly cleaning dryer lint traps, as accumulated lint can harbor spores and reduce airflow efficiency. Additionally, avoid overloading the dryer, as this prevents adequate heat distribution. For high-risk items like bedding or upholstery, consider using a steam cleaner, as steam temperatures (212°F or 100°C) can penetrate fabrics more effectively than dry heat. Finally, monitor infested areas for recurrence, as dormant spores can reactivate under favorable conditions.
In conclusion, while dryers operate within a temperature range that can reduce dungus spore populations, their natural heat resistance necessitates a more comprehensive approach. Combining high-temperature washing, prolonged drying, and targeted cleaning methods ensures a higher likelihood of eradication. By understanding the unique resilience of dungus spores, individuals can adopt strategies that go beyond conventional household practices, effectively mitigating infestations and preventing future outbreaks.
Are Spores Legal in Maryland? Understanding Current Laws and Regulations
You may want to see also
Explore related products

Fabric Material Role: How different fabrics affect spore survival during drying
The fabric you choose for your clothes can significantly influence the survival of dungus spores during the drying process. Natural fibers like cotton and linen, with their breathable and absorbent qualities, tend to trap moisture, creating a conducive environment for spores to thrive. In contrast, synthetic materials such as polyester and nylon are less absorbent, reducing the likelihood of spore survival. Understanding this material-specific behavior is crucial for anyone looking to minimize spore presence in their laundry.
Consider the following scenario: a cotton towel used in a humid environment is more likely to harbor dungus spores compared to a polyester towel under the same conditions. The reason lies in the fabric's ability to retain moisture. Cotton's hydrophilic nature allows it to absorb water, providing a damp environment where spores can remain viable. Polyester, being hydrophobic, repels water, making it less hospitable for spore survival. This simple comparison highlights the importance of fabric selection in spore management.
To effectively reduce spore survival during drying, follow these practical steps: first, opt for synthetic fabrics or blends with a higher synthetic content for items prone to moisture exposure. Second, ensure proper ventilation during the drying process to expedite moisture evaporation. For natural fiber garments, increase the dryer temperature to at least 130°F (54°C), as higher heat can help deactivate spores. However, be cautious with delicate fabrics, as excessive heat may cause damage.
A comparative analysis of fabric types reveals that while natural fibers offer comfort and breathability, they may require additional care to prevent spore survival. Synthetic fabrics, though less absorbent, can sometimes lack the comfort and aesthetic appeal of natural materials. Blended fabrics, combining the benefits of both, present a balanced solution. For instance, a cotton-polyester blend can provide the comfort of cotton while reducing moisture retention, thereby limiting spore survival.
In conclusion, the role of fabric material in spore survival during drying is a critical yet often overlooked factor. By choosing the right fabric and employing appropriate drying techniques, you can significantly reduce the presence of dungus spores in your laundry. Whether you prioritize comfort, durability, or spore management, understanding the unique properties of different fabrics will enable you to make informed decisions for a healthier and more hygienic laundry routine.
Are Mold Spores Harmful? Understanding Health Risks and Prevention Tips
You may want to see also

Alternative Methods: Other techniques to kill dungus spores if drying fails
While drying is a common method to combat dungus spores, it’s not always foolproof. High humidity, insufficient heat, or improper ventilation can render drying ineffective. In such cases, alternative methods become essential to ensure complete eradication. Here, we explore proven techniques that target spores with precision, offering reliable solutions when drying falls short.
Heat Treatment Beyond Drying: A Controlled Approach
One of the most effective alternatives is heat treatment, but not just any heat—it requires sustained, controlled temperatures. Exposing infested items to 120°F (49°C) for at least 30 minutes can kill dungus spores. This method is particularly useful for fabrics, furniture, or carpets that cannot withstand higher temperatures. Portable heat chambers or professional pest control services can ensure even distribution, eliminating the risk of spore survival in hidden areas. However, caution is necessary; prolonged exposure to high heat can damage delicate materials, so always assess the item’s heat tolerance beforehand.
Chemical Solutions: Targeted and Potent
For stubborn infestations, chemical treatments offer a direct approach. Boric acid, a natural mineral, is highly effective against spores when applied as a fine powder. Sprinkle it in affected areas, ensuring thorough coverage, and leave it for 24–48 hours before vacuuming. Alternatively, a solution of 91% isopropyl alcohol can be sprayed directly onto surfaces, killing spores on contact. For larger areas, fogging with a spore-specific biocide can penetrate cracks and crevices, ensuring no spore is left behind. Always wear protective gear and ensure proper ventilation when using chemicals, especially in enclosed spaces.
Natural Remedies: Harnessing the Power of Plants
For those seeking eco-friendly options, natural remedies can be surprisingly effective. Tea tree oil, known for its antifungal properties, can be diluted (10 drops per cup of water) and sprayed onto surfaces. Similarly, a solution of vinegar and water (1:1 ratio) can disrupt spore cell walls, though it may require repeated applications. These methods are safe for most surfaces and pose minimal health risks, making them ideal for households with children or pets. However, their efficacy may vary, and they are best used as preventive measures or in conjunction with other techniques.
Steam Cleaning: Deep Penetration, Instant Results
Steam cleaning combines heat and moisture to penetrate fabrics and surfaces, killing spores instantly. Using a steam cleaner at temperatures above 170°F (77°C) ensures spores are destroyed on contact. This method is particularly effective for upholstery, mattresses, and carpets, where spores often embed deeply. The added benefit of steam is its ability to sanitize without chemicals, making it a versatile and safe option. However, avoid using steam on water-sensitive materials like silk or certain types of wood, as it can cause damage.
Professional Intervention: When DIY Isn’t Enough
If all else fails, professional pest control services offer specialized treatments tailored to severe infestations. Experts use industrial-grade equipment, such as heat tents or fumigation, to ensure complete eradication. While this option is more costly, it provides peace of mind and guarantees results. Professionals can also identify underlying causes, such as moisture issues, and recommend preventive measures to avoid future infestations. For extensive or recurring problems, their expertise is invaluable.
By exploring these alternative methods, you can tackle dungus spores effectively, even when drying proves insufficient. Each technique offers unique advantages, and combining them can provide a comprehensive solution tailored to your specific needs.
Post-Winter Leaf Mold: Are Spores Lurking in Your Garden?
You may want to see also
Frequently asked questions
Yes, a dryer can effectively kill dungus spores if used correctly. High heat settings (above 130°F or 54°C) for at least 30 minutes are typically sufficient to eliminate spores.
Use the highest heat setting available on your dryer and run the cycle for at least 30 minutes. Ensure items are completely dry before removing them.
Air drying is not reliable for killing dungus spores. Heat is the most effective method, so using a dryer is recommended for thorough spore elimination.
Delicate fabrics or items labeled as "dry clean only" may be damaged by high heat. For these items, consult a professional cleaner or use alternative spore-killing methods like steam cleaning.